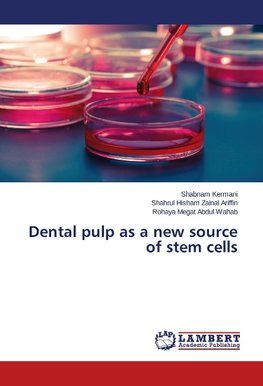
Dental pulp as a new source of stem cells

-
 Anglický jazyk
Anglický jazyk
Dental pulp as a new source of stem cells
Autor: Shabnam Kermani
Stem cells are one of the wonders of biology. Some of the reasons for using these cells include the possibility to save their proliferation during cell cycle and their ability to differentiate into various types of mature cells, whereas normal cell can only... Viac o knihe
Na objednávku
39.05 €
bežná cena: 41.10 €
O knihe
Stem cells are one of the wonders of biology. Some of the reasons for using these cells include the possibility to save their proliferation during cell cycle and their ability to differentiate into various types of mature cells, whereas normal cell can only give rise to its kind. Stem cells are divided into two with respect to their source viz embryonic stem cells and adult stem cells. Considering the limitations of working with embryonic stem cells, there is a growing interest among researchers to focus their studies on adult stem cells. Adult stem cells are found in many organs and tissues, but the important factor is the number of cells in each tissue is very limited. Accordingly, the present study investigates the cultivation of adult stem cells in dental pulp as a potential rich source of these cells. Dental pulp stem cells (DPSC) do not require general anesthesia during extraction as compared to bone marrow stem cells. They also have a very high proliferation rate when cultured and their properties are most closely related to the embryonic stem cells.
- Vydavateľstvo: LAP LAMBERT Academic Publishing
- Rok vydania: 2014
- Formát: Paperback
- Rozmer: 220 x 150 mm
- Jazyk: Anglický jazyk
- ISBN: 9783659561948












